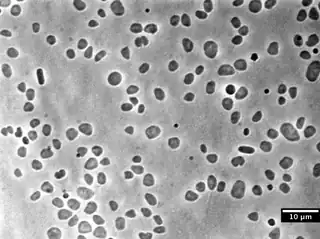

Haloarchaea
Haloarchaea —anteriormente denominado Halobacteria o Halomebacteria— es una clase de arqueas que se encuentran en el agua saturada o casi saturada de sal.[1] También son llamados halófilos extremos, aunque este nombre también se refiere a otros organismos que viven en medios con alta concentración salina. Crean mareas rojas con su pigmento bacteriorodopsina. Este pigmento lo utilizan para absorber la luz, que será la fuente de energía para crear ATP. Este proceso no está relacionado con otras formas de fotosíntesis. Son incapaces de fijar carbono a partir del dióxido de carbono.
| Haloarchaea | ||
|---|---|---|
| Rango temporal: 3500–0Ma Arcaico - Reciente | ||
Haloferax, una arquea pleomórfica | ||
| Taxonomía | ||
| Dominio: | Archaea | |
| Filo: | Euryarchaeota | |
| Clase: |
Haloarchaea DasSarma et DasSarma 2008 Halobacteria Grant et al. 2002 Halomebacteria Cavalier-Smith 1986 | |
| Órdenes y familias | ||
| ||
Las haloarqueas poseen vesículas de gas para flotar, por tanto son aeróbicas. En condiciones anaeróbicas se induce la síntesis de la membrana y las vesículas de gas para flotar en ambientes acuosos. La flotación aumenta con la disponibilidad de luz con el bombeo de electrones y con la fotofosforilación oxidativa.
Las haloarqueas pueden sobrevivir en ambientes salinizados, ya que tienen una vía separada de creación de energía aparte de la fotosíntesis. Algunas partes de la membrana celular de las haloarqueas son de color púrpura. Estas partes conducen las reacciones fotosintéticas con pigmento bacteriorodopsina en vez de la clorofila. Esto permite crear un gradiente de protones a lo largo de la membrana de la célula que le permite crear ATP para su propio uso.
Referencias
- Priya DasSarma and Shiladitya DasSarma 2008. On the origin of prokaryotic "species": the taxonomy of halophilic Archaea Archivado el 18 de mayo de 2014 en Wayback Machine. Saline Systems 2008, 4:5 doi:10.1186/1746-1448-4-5
Enlaces externos
 Wikispecies tiene un artículo sobre Haloarchaea.
Wikispecies tiene un artículo sobre Haloarchaea.- Taxones de la familia de las halobacteriaceas
- List of Prokaryotic Names with Standing in Nomenclature - Class Halomebacteria
- List of Prokaryotic Names with Standing in Nomenclature - Order Halobacteriales
- List of Prokaryotic Names with Standing in Nomenclature - Family Halobacteriaceae
- Clase Halobacteria Taxonomicon
- Halobacteria NCBI Taxonomy Browser